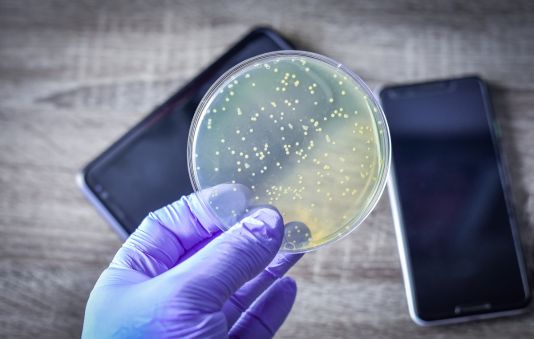
Smartphones als Keimschleudern

Inkontinenz ist mehr als ein medizinisches Problem – sie wirkt sich auf das Selbstwertgefühl, die Partnerschaft und die Intimität aus. Doch gemeinsam lassen sich viele Hürden meistern. Dieser Ratgeber zeigt, wie Paare offen mit dem Thema umgehen, Lösungen finden und ihre Beziehung stärken können.
Blog: Leben mit Inkontinenz
In dieser Kategorie finden Sie eine breite Vielfalt an Themen rund um Inkontinenz: Von medizinischen Neuerungen, persönlichen Erfahrungsberichten und praktischen Hilfsmitteln bis hin zu Alltagstipps sowie gesellschaftlichen und politischen Entwicklungen. Unsere Beiträge laden dazu ein, informiert zu bleiben, sich auszutauschen und Unterstützung zu finden – ganz gleich, ob Sie selbst betroffen sind, Angehörige begleiten oder beruflich interessiert sind.
- Details
- IKS e.V. - Blog
- Kategorie: Blog: Leben mit Inkontinenz
- Lesezeit: 7 Minuten
- Zugriffe: 184
Harninkontinenz betrifft viele Männer, besonders nach Prostataoperationen. Die gute Nachricht: Es gibt verschiedene moderne Systeme, die helfen können. Doch welches System passt zu wem? In diesem Beitrag stellen wir drei bewährte Methoden laienverständlich vor und zeigen die Unterschiede: das ATOMS-System, das AdVance-Band und den künstlichen Schließmuskel AMS 800.
Weiterlesen: Männliche Harninkontinenz: ATOMS, AdVance-Band und AMS 800 einfach erklärt
- Details
- IKS e.V. - Blog
- Kategorie: Blog: Leben mit Inkontinenz
- Lesezeit: 2 Minuten
- Zugriffe: 64
Blasenschwäche und Freizeitaktivitäten sind für viele Menschen eine Herausforderung – aber kein Grund, auf Lebensfreude zu verzichten. Wer an Blasenschwäche leidet, kann mit der richtigen Vorbereitung und Einstellung trotzdem ein aktives und erfülltes Leben führen. Hier findest du praktische Tipps, um trotz Blasenschwäche Freizeit zu genießen und neue Möglichkeiten zu entdecken.
- Details
- IKS e.V. - Blog
- Kategorie: Blog: Leben mit Inkontinenz
- Lesezeit: 14 Minuten
- Zugriffe: 262
Inkontinenz ist ein Thema, das viele Menschen betrifft – dennoch ranken sich zahlreiche Mythen und Irrtümer um Blasenschwäche und unkontrollierten Harnverlust. Diese Fehlinformationen führen oft zu Unsicherheit, Scham oder sogar dazu, dass Betroffene keine Hilfe suchen. In diesem Artikel klären wir die häufigsten Mythen über Inkontinenz auf und zeigen im Faktencheck was wirklich stimmt
Weiterlesen: Mythen über Inkontinenz: Faktencheck und Aufklärung
- Details
- IKS e.V. - Blog
- Kategorie: Blog: Leben mit Inkontinenz
- Lesezeit: 5 Minuten
- Zugriffe: 238
Smartphones begleiten uns überallhin – ob im Bus, beim Essen oder sogar auf der Toilette. Doch was viele nicht wissen: Die kleinen Alltagshelfer sind wahre Brutstätten für Bakterien und Keime. Studien zeigen, dass sich auf der Oberfläche von Smartphones oft mehr Keime befinden als auf einer öffentlichen Toilettensitzbrille.
Weiterlesen: Smartphones als Keimschleudern: Mehr Bakterien als auf der Toilette
- Details
- IKS e.V. - Blog
- Kategorie: Blog: Leben mit Inkontinenz
- Lesezeit: 5 Minuten
- Zugriffe: 141
Weiterlesen: Inkontinenz und Partnerschaft: Offene Kommunikation, Intimität und Tipps für Paare
- Details
- IKS e.V. - Blog
- Kategorie: Blog: Leben mit Inkontinenz
- Lesezeit: 5 Minuten
- Zugriffe: 67
Inkontinenz – ein Wort, das viele Menschen nicht einmal aussprechen möchten. Für Betroffene ist die Blasenschwäche weit mehr als ein körperliches Problem. Sie ist ein ständiger Begleiter voller Sorgen, Ängste und Unsicherheiten, die sich oft tief in den Alltag und die Seele eingraben. Doch warum fällt es so schwer, darüber zu sprechen? Warum bleibt Inkontinenz für so viele ein großes, belastendes Geheimnis?
Weiterlesen: Das große Schweigen: Warum Inkontinenz oft ein gut gehütetes Geheimnis bleibt
- Details
- IKS e.V. - Blog
- Kategorie: Blog: Leben mit Inkontinenz
- Lesezeit: 7 Minuten
- Zugriffe: 254
Antibiotikaresistenzen stellen eine wachsende Gefahr für die globale Gesundheit dar. Nicht Menschen, sondern Bakterien entwickeln Resistenzen gegen Antibiotika, wodurch herkömmliche Medikamente bei Infektionen zunehmend wirkungslos werden können. Die Ursachen liegen häufig im unsachgemäßen Gebrauch von Antibiotika, etwa durch zu häufige oder falsche Einnahme, aber auch durch den massiven Einsatz in Massentierhaltung und Krankenhäusern. Entscheidend zur Vorbeugung ist die gezielte Auswahl des passenden Antibiotikums nach Erregernachweis und das genaue Befolgen der ärztlichen Anweisungen. Wer Antibiotika nur bei echten bakteriellen Erkrankungen einnimmt und Rücksprache mit dem Arzt hält, hilft dabei, die Entstehung und Ausbreitung resistenter Keime einzudämmen und die Wirksamkeit dieser lebenswichtigen Medikamente für die Zukunft zu sichern.
Weiterlesen: Antibiotikaresistenz – das Wichtigste auf einen Blick
- Details
- IKS e.V.
- Kategorie: Blog: Leben mit Inkontinenz
- Lesezeit: 9 Minuten
- Zugriffe: 432
Inkontinenz bedeutet, dass Sie Ihre Blase oder Ihren Darm nicht mehr vollständig kontrollieren können. Das Resultat ist ein ungewollter Urin- oder Stuhlabgang – oder auch eine sogenannte Entleerungsstörung. Inkontinenz kann jeden treffen und beeinträchtigt sowohl die körperliche als auch die seelische Gesundheit spürbar.
Weiterlesen: Inkontinenz: Ursachen, Formen, Symptome & Behandlung
- Details
- IKS e.V. - Blog
- Kategorie: Blog: Leben mit Inkontinenz
- Lesezeit: 8 Minuten
- Zugriffe: 302
Inkontinenz im Berufsleben betrifft Millionen Menschen – und doch bleibt das Thema oft hinter verschlossenen Türen. Die Angst, entdeckt zu werden, der Stress, rechtzeitig zur Toilette zu kommen, und die Furcht vor peinlichen Situationen gehören für viele zum Alltag. Dabei zählt für Betroffene meist nur eines: Bloß niemandem davon erzählen.
Weiterlesen: Berufstätig mit Inkontinenz: Warum Offenheit entlastet
- Details
- IKS e.V. - Blog
- Kategorie: Blog: Leben mit Inkontinenz
- Lesezeit: 2 Minuten
- Zugriffe: 271
Inkontinenz betrifft nicht nur den Körper, sondern auch die Seele. Viele Menschen fühlen sich mit ihrer Blasen- oder Darmschwäche alleingelassen und kämpfen Tag für Tag mit Gefühlen wie Scham oder Frustration. Diese psychische Belastung ist absolut nachvollziehbar – doch du bist damit nicht allein! In diesem Artikel liest du, wie du mit diesen Emotionen umgehen und dir Unterstützung holen kannst.
Weiterlesen: Psychische Gesundheit: Scham und Frustration bei Inkontinenz
- Details
- IKS e.V. - Blog
- Kategorie: Blog: Leben mit Inkontinenz
- Lesezeit: 5 Minuten
- Zugriffe: 410
Inkontinenz ist ein sensibles Thema, das viele Menschen betrifft – unabhängig von Alter oder Lebenssituation. Sie stellt jedoch längst kein Hindernis mehr für modische, selbstbewusste und individuelle Kleidung dar. Moderne Materialien, innovative Schnitte und clevere Kombinationstipps sorgen dafür, dass Betroffene sich rundum wohlfühlen, ohne auf Stil und Diskretion verzichten zu müssen. Im Folgenden finden Sie ausführliche Empfehlungen und praktische Anregungen für einen selbstsicheren und stilvollen Alltag.
Weiterlesen: Modische und diskrete Kleidungstipps für Inkontinenz-Betroffene
- Details
- IKS e.V. - Blog
- Kategorie: Blog: Leben mit Inkontinenz
- Lesezeit: 4 Minuten
- Zugriffe: 431
Die intermittierende Selbstkatheterisierung (ISK) ist für viele Betroffene ein wichtiger Bestandteil des Alltags. Gute Hygiene ist dabei essenziell, damit der Ablauf sicher, einfach und möglichst frei von Komplikationen bleibt. Dieser Ratgeber beantwortet häufige Anwenderfragen, gibt praktische Tipps und stellt bewährte Hilfsmittel vor.
Weiterlesen: Hygienetipps & praktische Helfer für die intermittierende Selbstkatheterisierung (ISK)